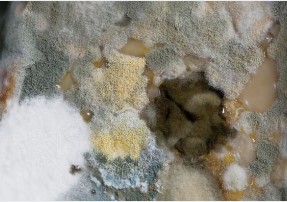

티스토리 뷰
목차
안녕하세요. 여러분 가정에 생활비 30만 원 절약해 줄 독일이 씨입니다. 요즘 어느 때보다 무더운 날을 보내고 계시지요?
■ 그런데 혹시 오뉴월에 뭐도 안 걸린다는 감기로 고생하고 있지는 않으신가요? 무더운 날씨인데도 우리 아이들이 콧물과 기침을 달고 살지는 않으신가요? 아내나 남편은 담배를 피우지 않는데도 기침에 가래로 고생을 하고 있지는 않은가요?
■ 저 또한 일주일을 약을 먹었는데도 여전히 기침가래로 어려움을 겪고 있는데요.
혹시나 하는 마음으로 저희 집 에어컨을 살펴보았더니 에어컨의 먼지가 이렇게 쌓여 있었습니다.



■ 이런 에어컨에서 나오는 바람을 그대로 쐬고 있었으니 에어컨 바람에서 나오는 병균들이 아마 그대로 우리 아이의 몸속이나 사랑하는 아내 혹은 남편의 몸을 더욱 힘들게 했는지 모르겠습니다.
■ 에어컨의 내부를 좀 더 살짝 들여다 보면 이런 곰팡이가 피어있는 것을 보실 수 있을 실 텐데요.

■ 이런 곰팡이는 아이들에게 알레르기 반응이나 호흡기에 상당한 문제를 일으킬 수 있을 뿐만 아니라 면역력이 약한 유아나 나이가 많으신 어르신들에게는 특히나 더 나쁜 영향을 끼칠 수 있습니다.
■ 그렇기 때문에 우리집 에어컨에서 냄새가 난다거나 눈으로 확인을 하였을 때 먼지가 상당히 끼어 있다면 빨리 에어컨 청소를 통해 실내 공기를 쾌적하게 만들어 주는 것이 온 가족의 건강을 위해 올바른 선택일 것입니다.



■ 그래서 어차피 청소를 해야 한다면 하루라도 빨리 청소를 하기로 마음을 먹었습니다.
■ 이리저리 수소문을 하고 에어컨 청소 가격을 알아봤는데 동네 사설 업체는 업체마다 가격이 다르더라고요. 요즘 같은 불경기에 단돈 1~2만 원이 아쉬운 요즘인데 어떻게 해야 정말 합리적인 가격에 깨끗한 에어컨 케어를 받을 수 있을까?
■ 어떤 금액이 에어컨 청소하는데 합리적인 금액일까? 고민해 보았습니다. 그리고 우리나라 에어컨의 대표적인 업체 두 군데와 사설 업체의 가격을 비교하며 어떤 케어를 받을 수 있는지도 알아보았습니다.
■ 아마 여러분들도 청소 전과 청소 후를 비교해 보신다면 에어컨 청소가 얼마나 중요한지 금방 아실 수 있으실 거예요.




■ 위의 사진과 같이 곰팡이가 잔뜩 끼어 있는 에어컨에는 우리 가족의 건강을 해칠만한 온갖 득실거리는 세균들로 인해서 소중한 우리의 사랑하는 자녀들이 건강을 해칠 우려가 있다면 빨리 에어컨 청소를 해야겠지요.
■ 아래의 비교표를 보시고 여러분 동네에서 요구하는 에어컨 케어 비용이 얼마인지 비교해 보셔서 바가지 쓰시지 마시고 단돈 만원이라도 아낄 수 있는 기회가 되셨으면 좋겠습니다.
■ 건강은 누군가가 챙겨줘야 하는 때가 왔다면 늦습니다. 누군가가 챙겨주어야 하기 전 내가 할 수 있을 때 준비해야 합니다.
사설업체 청소비용



■ 일반 사설업체의 평균적인 가격이며 여러분이 살고 있는 지역이나 아파트 평형에 따라 가격은 상이할 수 있습니다.
| 업체 | 유형 | 평균비용 |
| 사설 | 벽걸이 | 70,000~90,000 |
| 스텐드 | 90,000~150,000 | |
| 천장형 | 90,000~170,000 |
■ 구체적인 일반사설업체 청소비용은 아래 표를 참고하시고 삼성, LG에어컨의 케어 비용은 좀 더 아래에 비용과 케어 절차를 사진으로 남겨 두었으니 참고하시기 바랍니다.
삼성에어컨 청소비용
| 업체 | 유형 | 평균비용 |
| 섬성에어컨 | 벽걸이 | 109,000 |
| 스텐드 | 171,000 | |
| 천장형 | 174,000 | |
| 홈멀티 | 280,000 |
삼성에어컨 유형별 가격표
삼성에어컨 케어순서








■ 제품 상태를 점검하고 사후관리 약속까지 8단계를 거쳐 꼼꼼하게 케어하는 삼성은 브랜드의 가치를 이미 잘 알고 있기 때문에 믿고 맡길 수 있는 케어서비스입니다.
청소 후 제품상태


■ 실제 청소 전후의 사진입니다. 이 정도 케어라면 믿을만하겠지요.
삼성에어컨 케어 효과


■ 청소 후 에어컨이 깨끗해진 것뿐만 아니라 에너지 절약과 에어컨의 효율성까지 높아진 것을 확인할 수 있었습니다.
LG에어컨 청소비용
| 업체 | 유형 | 평균비용 |
| LG에어컨 | 벽걸이(전제품) | 110,000 |
| 스텐드(가정용) | 170,000 | |
| 창호형, 이동식(전제품) | 110,000 |
LG에어컨 케어 순서








■ 위의 서비스는 스탠드에어컨의 예시이며, 제품 및 모델에 따라 서비스 범위가 달라질 수 있습니다.
■ 에어컨 케어 소요 시간은 120분 외로 소요됩니다.
■ 제품 상태를 점검하고 정상작동 점검까지 약속까지 8단계를 거쳐 꼼꼼하게 케어하는 LG는 브랜드의 가치를 이미 잘 알고 있기 때문에 믿고 맡길 수 있는 케어서비스입니다.
한눈에 비교 견적
| 업체 | 유형 | 평균비용 |
| 사설업체 | 벽걸이 | 70,000~90,000 |
| 스텐드 | 90,000~150,000 | |
| 천장형 | 90,000~170,000 |
| 업체 | 유형 | 평균비용 |
| 섬성에어컨 | 벽걸이 | 109,000 |
| 스텐드 | 171,000 | |
| 천장형 | 174,000 | |
| 홈멀티 | 280,000 |
| 업체 | 유형 | 평균비용 |
| LG에어컨 | 벽걸이(전제품) | 110,000 |
| 스텐드(가정용) | 170,000 | |
| 창호형, 이동식(전제품) | 110,000 |
■ 올여름 에어컨 청소로 온 가족 건강한 여름 보내시고 좋은 업체 선정으로 가계비 부담은 줄이고 에어컨 효율은 높이는 건강하고 행복한 여름 보내세요.